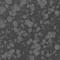
Black

Loading
Loading
Loading
Loading
Loading
Loading
Loading
Loading
Loading
Loading
Loading
Loading
Loading
Quantity
The Alchimie collection possesses a seemingly ancient and luxurious patina that brings a timeless glow to any table setting. Individual pieces are crafted from fine earthenware and enhanced by a unique reactive finish.
The Alchimie collection possesses a seemingly ancient and luxurious patina that brings a timeless glow to any table setting. Individual pieces are crafted from fine earthenware and enhanced by a unique reactive finish.
You May Also Need
Quantity
Quantity
Quantity
Quantity
Quantity
Quantity
Quantity
Quantity
Quantity